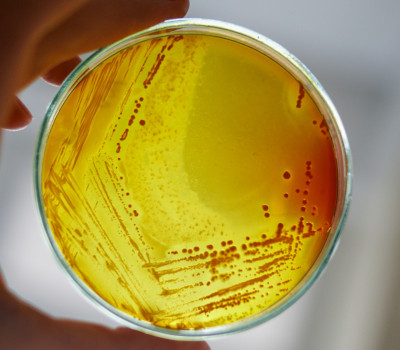

Financial Support Available
ACTF Summer Studentships

Financial support for 6-8 week long summer studentships in the UK and RoI, to provide undergraduate students the opportunity to learn new analytical science skills.
DEADLINE: Call for 2026 is now closed.
CAMS Fellowships

To assist early career analytical chemists within 5 years of their first full-time junior academic appointment at a UK or Irish HEI to establish their own independent analytical science research.
DEADLINE: Call is now open. Deadline for application has been extended to 17:00 on the 11th September 2026
Overseas Conference Travel Grants

These grants are designed to assist postgraduate PhD students who are engaged in analytical research projects to attend and actively participate in overseas scientific conferences.
DEADLINE: OPEN (Reviewed monthly)
Food Analytics Conference Travel Grant
Up to £500 to help PhD students and early career researchers attend the Food Analytics Conference held in Copenhagen, for travel and subsistence costs.
DEADLINE: Call is now closed.
RSC ASC Region Grants

ACTF will provide annual grants of £1000 to any RSC Region with <£10,000 in their accounts at the beginning of the calendar year.
DEADLINE: Open. Reviewed on receipt of application
Low/Middle Income Economy Scholarships

Project sponsorship for international scholars to travel to the United Kingdom to learn analytical skills, for up to 3 months, before returning to their home country to share what they have learned.
DEADLINE: Call for 2026 is now open
Outreach Scholarships

To provide the opportunity for analytical scientists that are citizens of the UK or RoI, to visit a Host Institution in a Developing World country to disseminate new analytical science knowledge.
DEADLINE: OPEN (Reviewed quarterly)
Ad-Hoc Applications

The ACTF will consider ad-hoc applications for funding for small projects throughout the year, that support the analytical science community in the UK and Republic of Ireland. Please note these awards are not intended to bolster existing funding for research projects or studentships.
DEADLINE: OPEN (Reviewed quarterly)
Study Leave Grant Scheme

For Analytical Scientists who are employed in university, industrial or public service sectors to visit a Host Institute to acquire new analytical science knowledge, or experience of analytical science teaching, learning or training methods, which would be applied on return to normal employment.
DEADLINE: Call for 2026 is now open
Case Studies

The funding provided by the ACTF allows us to run the Emerging Analytical Professionals (EAP) conference, which is a forum for fostering and promoting networking opportunities as well as gaining experience in the delivery of poster pitches and presentations. The conference also furthers the delegates analytical knowledge by hearing from early career scientists, as well as invited speakers from academia and research backgrounds. The event provides valuable learning opportunities in a relaxed and supportive environment, which allow the attendees to gain experience that they can take forward through their career and future conference attendance. The ACTF’s funding is invaluable, and we are incredibly appreciative of their continued contributions and support towards the ASN.
-Harriet Pembroke, ASN Chair

The ACTF scholarship allowed me to travel to Uganda to learn more about the burden tuberculosis (TB) and its treatment has on the Ugandan population. Drug-induced liver injury (DILI) is a major obstacle to effective TB therapy and if it occurs the life-saving treatment must stop and can only commence when the liver function returns. DILI is hard to determine in resource-limiting settings and there is an unmet need for point-of-care platforms to assess DILI. Working with our collaborators at Makerere University, we carried out a pilot study to evaluate if a point-of-care test could detect DILI in serum samples from patients undergoing TB treatment. Positive results for all patients who had elevated DILI biomarker levels were achieved demonstrating that the test could be used to successfully detect DILI in this cohort. Overall, the visit was a great success and will hopefully lead to a successful translation of the point-of-care test in Uganda.’
Dr. Sian Sloan-Dennison MRSC (She/Her)
Supported Projects/Previously Funded
Schools’ Analyst Competition
The Schools’ Analyst Competition enables school students to demonstrate and expand on their existing chemistry knowledge, skills and aptitude for analytical science through practical analytical experiments based on relevant societal or industrial problems.
The Analytical Science Network
The Analytical Science Network, is designed to foster the careers of present and prospective early career analytical scientists in the UK, including running their flagship conference “Emerging Analytical Professionals”, which typically takes place in annually in May.
CAMS
The ACTF has provided significant financial investment in the Community for Analytical Measurement Science (CAMS), including secretariat support, and fellowship funding.
Covid-19 Disruption Grants
An ACTF initiative, the Covid-19 disruption grants were established to help PhD students struggling financially and whose studies had been impacted due to the onset of the Covid-19 pandemic. During 2021 and 2022, ACTF provided grants of £500 per individual.
